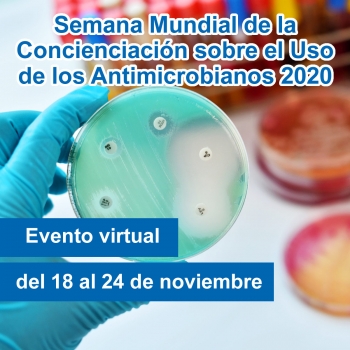
Semana Mundial de la Concienciación sobre el Uso de los Antimicrobianos 2020

Últimos registros
-
NORMATIVAS Y PROCEDIMIENTOS PARA EL LICENCIAMIENTO AMBIENTAL DE ACTIVIDADES Y PROYECTOS CON PLAGUICIDAS QUIMICOS DE USO AGRICOLA - PQUAS
Ciudad:
Lugar: Virtual(Zoom)
Organiza: APIA
Telefono: 33420735 - 78453292
 2022-06-23
2022-06-23 -
Semana Mundial de la Concienciación sobre el Uso de los Antimicrobianos 2020
Ciudad:
Lugar: Vitual
Organiza: SENASAG
Telefono:
 2020-11-18
2020-11-18 -
Evento Campo Limpio 2019
Ciudad: Santa Cruz de la Sierra
Lugar: Salón “Juayhu” del Hotel Camino Real de la ciudad de Santa Cruz (Av. San Martín y 4to. Anillo, No. 2130)
Organiza: APIA
Telefono:
 2019-10-30
2019-10-30 -
Taller de Capacitación y Acreditación "Ejecución de Pruebas de Eficacia de Plaguicidas Químicos de Uso Agrícola con fines de registro"
Ciudad: Santa Cruz de la Sierra - Bolivia
Lugar: Hotel Camino Real
Organiza: SENASAG
Telefono:
 2018-11-13
2018-11-13 -